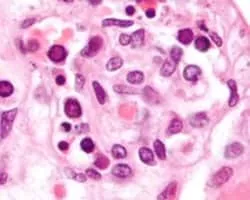

Parvovirus
| Use attributes for filter ! | |
| Scientific name | Parvovirus |
|---|---|
| Rank | Genus |
| Phylum | incertae sedis |
| Order | Incertae sedis |
| Higher classification | Parvoviridae |
| Date of Reg. | |
| Date of Upd. | |
| ID | 1103936 |
About Parvovirus
Parvovirus is the common name applied to all the viruses in the Parvoviridae taxonomic family, although it can also be used specifically for members of one of the two Parvoviridae subfamilies, the Parvovirinae, which infect vertebrate hosts.